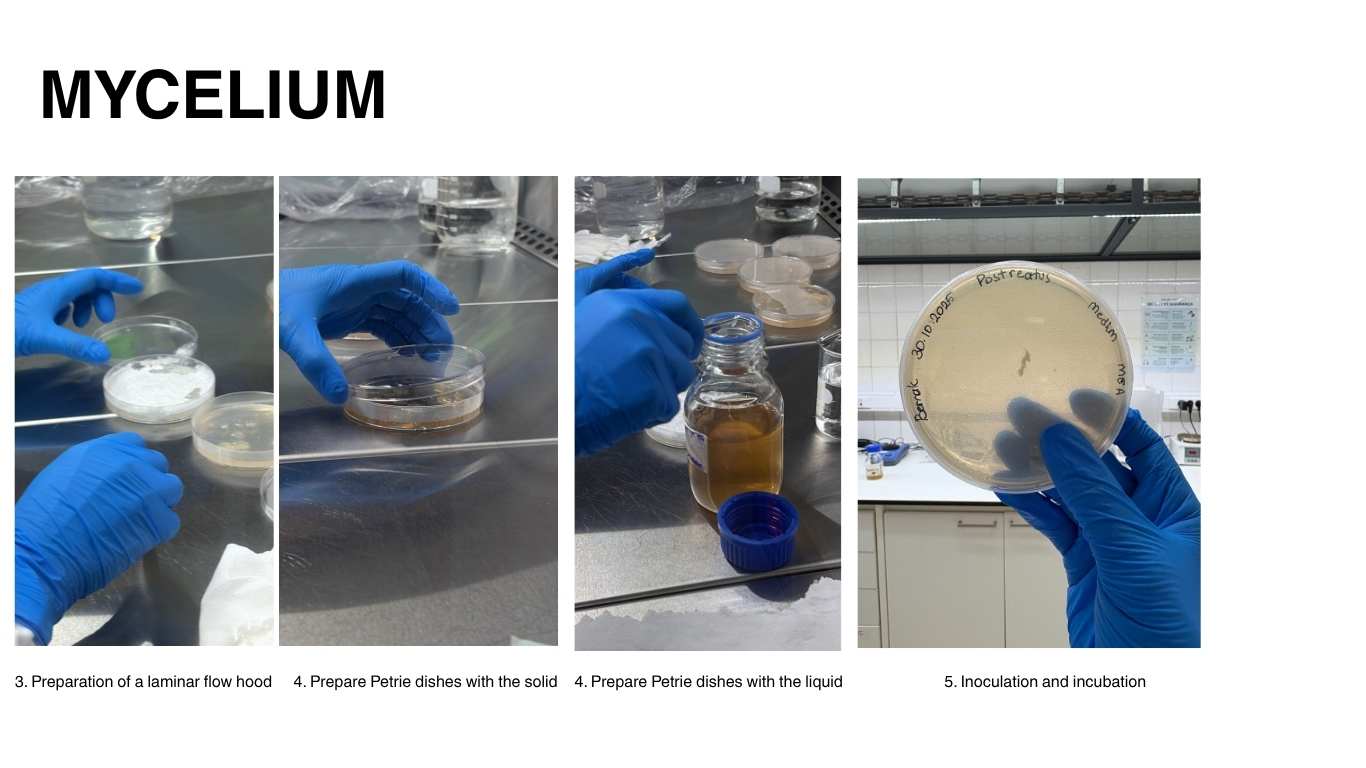
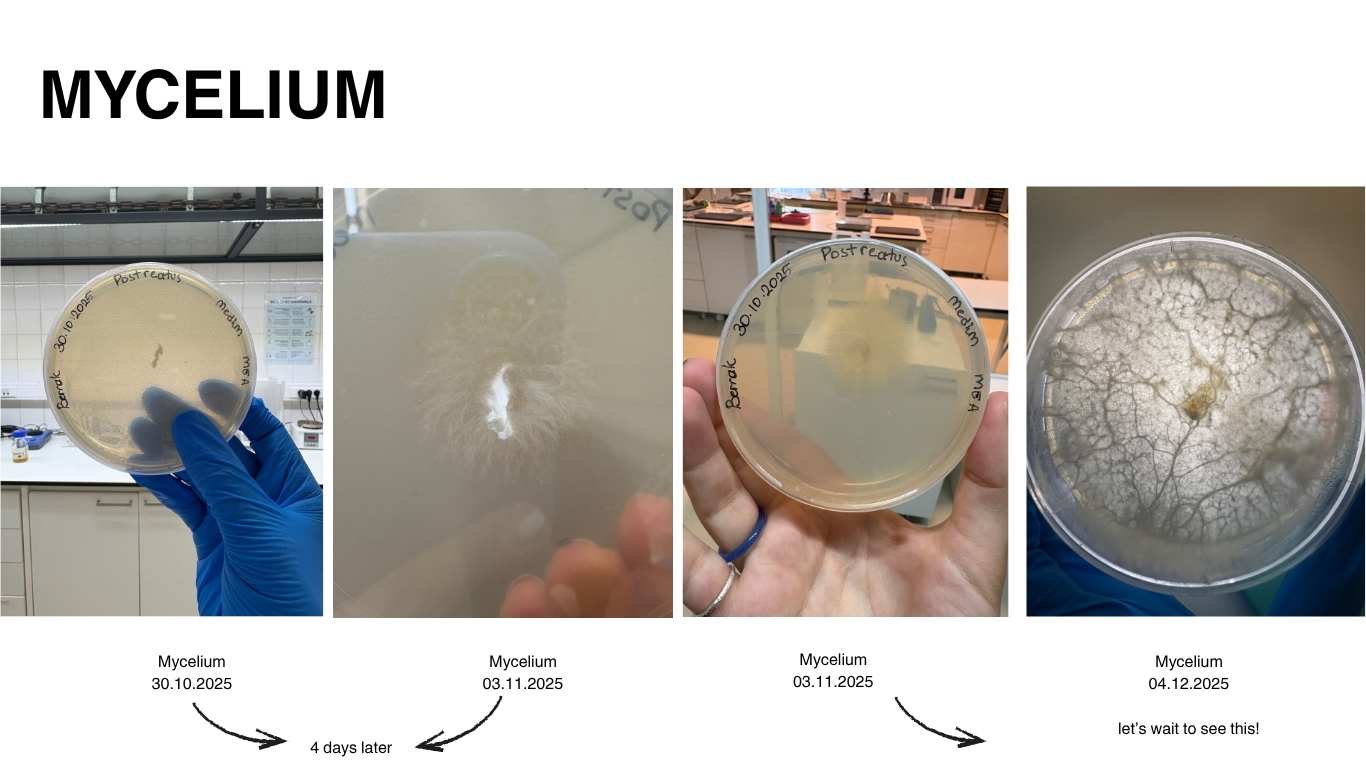
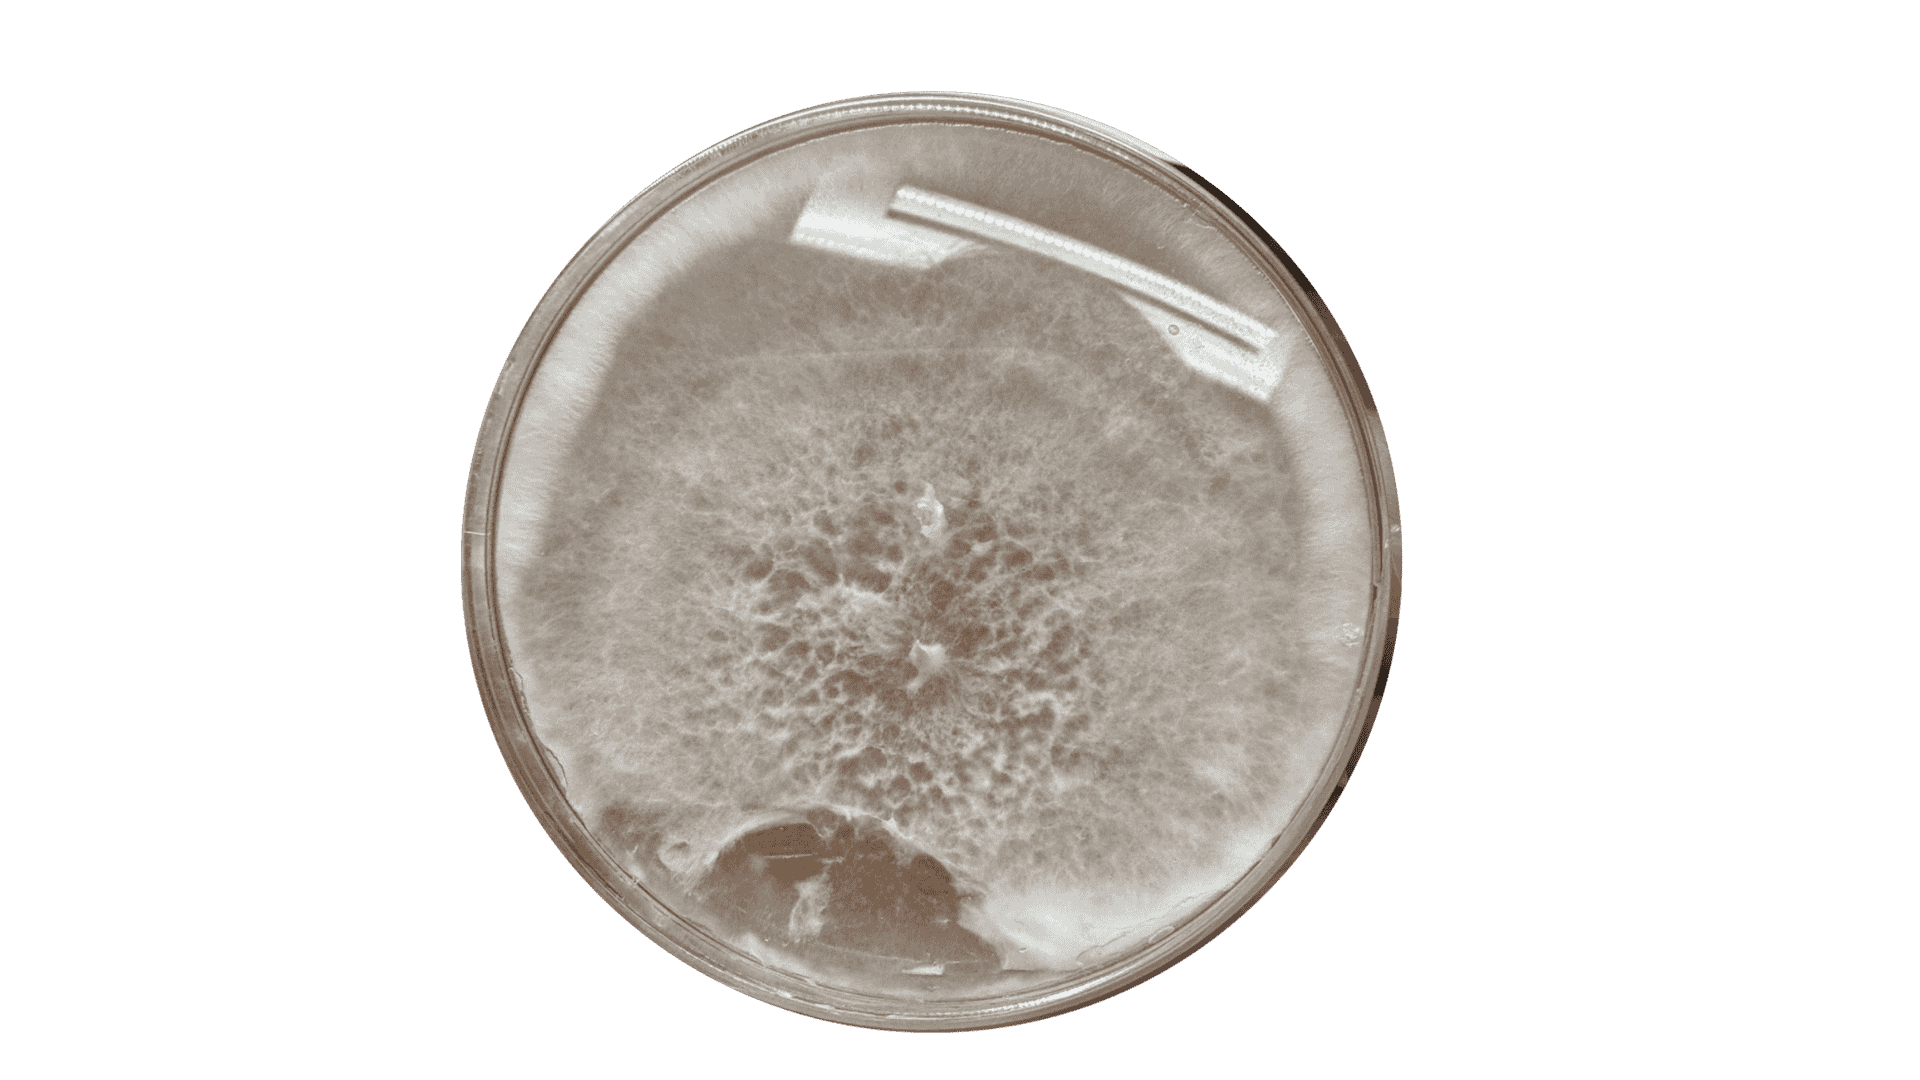

7. BioFabricating Materials¶
Bioyarn Crochet by Berrak Zeynep Okyar and Inci Muhaddis
Spirulina Bio-yarn Knitting by Berrak Zeynep Okyar
Global class by Cecilia Raspanti from TextileLab Amsterdam at Waag.
Local Class by Carolina Delgado and Magda Barreira
WEEKLY ASSIGNMENT¶
- Include some inspiration: research on artists, projects, platforms that work with biomaterials, local ingedients and resources
Produce at least one crafted and one grown material:
-
Crafted material - explore the different recipes and understand how to adjust them based on the ingredients
-
Grown material - explore the different recipes and understand how to adjust them based on the ingredients
-
Document your recipes, the ingredients and process and if there have been changes, document your unexpected discoveries
-
Name your materials, classify them by typology and display them in a systematic order of samples
-
Submit some of your swatches to the analog material library of your lab. (20cm x 20cm approx.)
INSPIRATION¶
Bioyarn Crochet by Berrak Zeynep Okyar
RESEARCH¶
PHOTOGRAPH BY VINCENT KNEEFEL
- WHAT ARE PLASTICS?¶
Reference: Bio Materials Workshop Presentation by Carolina Delgado
Plastic is a polymer and is usually combined with one or more of the following components:
• Plasticizer: Provides flexibility.
• Filler: Prevents the material from shrinking.
• Stiffening agent: Strengthens and reinforces the structure of the material.
• Expanding agent: Creates a foam form.
• Pigments: Add color or make the material opaque
Reference: Bio Materials Workshop Presentation by Carolina Delgado
8 ISSUES OF PLASTICS / SYNTHETICS¶
1.NEVER GOES AWAY
Plastic is a material made to last forever, yet 33 percent of all plastic – water bottles, bags and straws – are used just once and thrown away. Plastic cannot biodegrade; it breaks down into smaller and smaller pieces.
2.AFFECTS HUMAN HEALTH
Toxic chemicals leach out of plastic and are found in the blood and tissue of nearly all of us. Exposure to them is linked to cancers, birth defects, impaired immunity, endocrine disruption and other ailments.
3.SPOILS OUR GROUNDWATER
There are thousands of landfills. Buried beneath each one of them, toxic chemicals from plastics drain out and seep into groundwater, flowing downstream into lakes and rivers.
4.ATTRACTS OTHER POLLUTANTS
Chemicals in plastic which give them their rigidity or flexibility (flame retardants, bisphenols, phthalates and other harmful chemicals) are oily poisons that repel water and stick to petroleum-based objects like plastic debris. So, the toxic chemicals that leach out of plastics can accumulate on other plastics. This is a serious concern with increasing amounts of plastic debris accumulating in the world’s oceans.
5.THREATENS WILDLIFE
Wildlife become entangled in plastic, they eat it or mistake it for food and feed it to their young, and it is found littered in even extremely remote areas of the Earth. In our oceans alone, plastic debris outweighs zooplankton by a ratio of 36-to-1.
6.PILES UP IN THE ENVIRONMENT
Americans discard more than 30 million tons of plastic a year. Only 8 percent gets recycled. The rest ends up in landfills, is burned or becomes litter.
7.POISONS OUR FOOD CHAINS
Even plankton, the tiniest creatures in our oceans, are eating microplastics and absorbing their hazardous chemicals. The tiny, broken-down bits of plastic are displacing the algae needed to sustain larger sea life who feed on them.
8.COSTS BILLIONS TO ABATE
Everything suffers: tourism, recreation, health of humans, animals, fish and birds — because of plastic pollution. The financial damage continuously being inflicted is inestimable.
Reference: 8Issuesofplastics
- WHAT ARE BIO-MATERIALS?¶
Our design approach focuses on creating materials that are designed to be recycled, disassembled, repaired, and remanufactured. Therefore, we study how to plan materials throughout their entire life cycle from their origin to their end of use, from application to disposal and how they can eventually return to the building blocks that our planet can naturally digest.
Focus on 3 main concepts:
Bio-based
Biodegradable
Biocompostable materials.
Reference: Global class Presentation by Cecilia Raspanti from TextileLab Amsterdam at Waag.
Bio-based materials are derived from living sources such as plants, bacteria, fungi, minerals, animals, or human-made biological components.
However, being bio-based does not necessarily mean being environmentally friendly, since many substances found in nature are also toxic. Thus, bio-based does not automatically equal sustainable.
Biodegradable materials can break down under specific environmental conditions, such as changes in temperature, pH, or through the action of enzymes.
They are often pH-sensitive, thermosensitive, or enzyme-degradable. This means that a biodegradable product will not always decompose in a household compost bin — it requires certain controlled conditions. Nevertheless, such materials are valuable as alternatives to conventional plastics.
Biocompostable materials, on the other hand, can be broken down by naturally occurring bacteria, mycelium (fungal root networks), or small organisms within approximately 90 days. When placed in the soil, a compost pile, or water, these materials gradually disintegrate and can even nourish the environment, closing the biological loop.
Reference: Bio Materials Workshop Presentation by Carolina Delgado
Reference: Bio Materials Workshop Presentation by Carolina Delgado
- HOW TO CRAFT BIO-MATERIALS?¶
We currently work with materials that are used, prepared, and reach their end of life.
However, our goal is to move toward a system that focuses on
Recycling-> decomposing->regenerating->reassembling.
Photo by Berrak Zeynep Okyar
1.Bioplastics
We will look into agar and alginate bioplastics, as well as gelatin-based, vegetal-based, and waste-derived bioplastics.
2.Alternative Leathers
This section focuses on:
• Microbial and mycelium leathers, both cultivated in biolab environments. • Vegetal leathers, animal waste leathers, fruit leathers, and lab-grown high-tech leathers.
While not all laboratories can produce these, they serve as valuable case studies for understanding different material fabrication methods.
3.Biofabrics and Yarns
We will explore materials derived from plant matter, rooted in nature and sometimes using domesticated roots to create new fibers. We also consider animal and even human-based resources — questioning whether we ourselves could become a resource for material creation. This category includes natural fibers and fabrics, as well as technologically spun and extruded yarns.
RECIPES¶
Gelatine - Bioplastics¶
Reference : Bio-materials Workshop by Carolina Delgado
ALGINATE¶
Algae are simple organisms that live in water. They can perform photosynthesis.
They are living commonly freshwater, oceans or moist soil.Algae include both microalgae and macroalgae.Estimated to be 72,500 algal species on Earth.Algae produces half of all of the oxygen in the Earth’s atmosphere. They absorb carbon dioxide and produce oxygen. Algae can grow very fastly. Seaweed - Kelp ( type of brown algae) can grow up to 1 meter in a day.
Reference :Brown Algae
ALGINATE - BIOCOMPOSITES¶
ALGINATE BIOPLASTICS - BIOFILM & BIO-YARN¶
Photo by Berrak Zeynep Okyar
MYCELIUM INOCULATION¶
- Preparation of Culture Media
1.1 Liquid Medium (Malt Extract Broth) • Malt extract – 4 g • Distilled water – 200 mL
→ Mix well, sterilize at 121°C for 40 minutes, and allow to cool before inoculation.
1.2 Solid Medium (Malt Extract Agar) • Malt extract – 1.6 g • Agar – 1.6 g • Distilled water – 80 mL
→ Dissolve completely, sterilize at 121°C for 40 minutes, pour into Petri dishes, and store at 4°C.
- Preparation of the Laminar Flow Hood
I. Cleaning and Setup • Switch on the laminar flow hood. • Clean all inner surfaces using 70% ethanol: • Side walls • Metal work surface • Front glass • Underside of the work surface (if needed) • If necessary, also wipe the outer surfaces with 70% ethanol.
II. Placement of Materials • Arrange all sterilized and required materials inside the hood before starting work. • Organize them efficiently to minimize unnecessary movement during procedures.
III. UV Decontamination • Close the hood and run the UV light for 15 minutes to ensure proper decontamination of the working area. 3. Inoculation • Perform inoculation under aseptic conditions within the laminar flow hood. • Ensure all instruments and materials remain sterile throughout the process. 4. Incubation • Transfer inoculated plates and flasks to an incubator set at 26°C. • Maintain stable temperature and monitor growth as required. 5. Post-Work Cleaning • After completing the procedure, clean the laminar flow hood again using 70% ethanol on all internal surfaces. • Allow the hood to dry before closing or covering.
References and Mentoring:This protocol was taught and supervised by Magda Barreira -Biolab Lisboa
CASEIN FIBRES¶
Casein-Based Sustainable Materials: Fibre & Bioplastic Protocol
- Introduction
Casein, the main milk protein (≈80%), can be extracted from spoiled or surplus milk and used to produce fibres or bioplastics. This process supports circular economy principles by transforming waste into valuable raw material.
- Casein Fibre Production
2.1 Isolation 1. Heat 500 mL skimmed milk to 52°C while stirring. 2. Add 50 mL vinegar slowly to precipitate casein. 3. Filter and wash the curds with 200 mL distilled water. 4. Dry overnight at room temperature and store in a sealed container.
Note: Other acids (citric, lactic) can be used if safe and compatible.
2.2 Fibre Formation 1. Mix glycerol (99.8%) and distilled water (1:1). 2. Add casein powder, then paraffin oil or wax for flexibility. 3. Adjust pH to 6.5 with 0.5 M NaOH. 4. Heat to 65°C and extrude through a nozzle to form fibres.
Care: Handle gently, wash with neutral detergent, avoid bleach or high temperatures.
- Casein Bioplastic Production
- Heat 500 mL whole milk to 40–50°C (no boiling).
- Add 4–5 tbsp vinegar or another mild acid to form curds.
- Filter and rinse the curds with distilled water.
- Mix with glycerol (1 tsp per 100 mL milk) until smooth. Optional: add natural pigments (spirulina, turmeric, etc.).
- Spread 1–3 mm thick on trays and dry at room temp (24–72 h) or 30–40°C.
- Once hardened, cut, polish, or coat with wax/shellac for finish.
Protocol taught and supervised by Magda Barreira.
Documenting and comparing experiments¶
TEST SERIE BIO-PLASTIC¶
RESULTS¶
Biomaterials by Berrak Zeynep Okyar